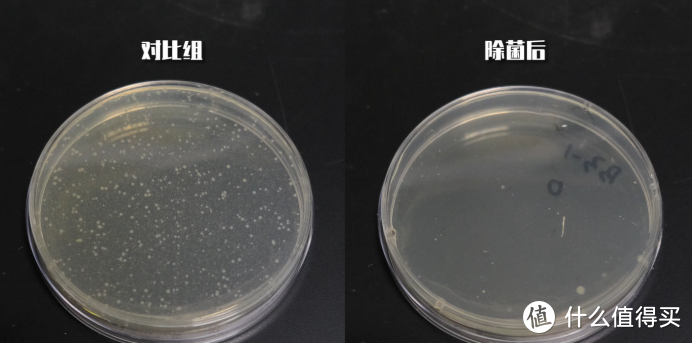
除螨仪强拍打功能真能去除螨虫吗？专业评测用数据说话更安心！

如今是网络时代,是躺在床上就能买遍全球的移动便捷化生活。“选择好东西”是这个时代的态度。但是对于家电产品来说,它的选择就不是“看起来很美”那么简单了。夸张的宣传、相似的卖点、性能背后看不懂的参数、被刷出的好评率……而你的选择直接关系到幸福指数是攀升还是坠入深渊。
当然,还有一种方式可以让你的选择更从容——认准中国家用电器研究院设计研究与评测中心的“嘉电”认证。“嘉电”依托中国家用电器研究院设计研究与评测中心先进的评测实验室和专业的评测技术规范,深度挖掘优秀的家电产品,为广大消费者的实际购买行为提供更准确、更权威、更科学的指导意见。

莱克吉米B302Pro除螨仪凭强劲拍打,超大吸力和深层除螨等功能获得多项荣誉且销量达30万台,有良好的市场口碑。中国家用电器研究院环境与健康相关产品检测所对这款除螨仪进行了检测,强拍打+大吸力真的可以达到高效除螨吗?通过一系列科学严谨的测试方法,得出产品最真实的数据。

莱克吉米除螨仪家用床上小型紫外线杀菌机莱克吸尘器去除螨虫神器419元天猫精选去购买根据中国家用电器研究院健康家电与相关产品检测所对于莱克吉米B302Pro除螨仪的测评报告显示,在大吸力的基础上拥有强力拍打功能时除螨率提升近30%!兼具大吸力,强拍打,紫外线杀菌和超声波抑螨功能的专业除螨仪是未来除螨仪的发展方向。
具体是怎样得出这样的测评结论呢?我们走进实验室一探究竟。


目前在天猫商城上销量第一的莱克吉米B302Pro号称的强拍打功能真的能够去除螨虫吗?和市面上其他只具有大吸力的除螨仪有什么差别呢?我们在中国家用电器研究院环境与健康相关产品检测所的实验室来验证一下。
除螨仪的拍打功能

·在试验布中铺洒约5000只螨虫活体

·QB/T5363-2019《除螨机》标准试验
依照QB/T5363-2019《除螨机》测试方法,在黑色实验布上铺洒5000(±500)只活体螨虫,然后再在上面铺盖白色实验布,并固定在操作台上。

将莱克吉米B302Pro除螨仪打开进行往复除螨操作30次。分别测试搭载/不搭载拍打模块的产品除螨效果,最后对比实验布上的剩余螨虫数量和除螨率。


通过测试可以看出,在莱克吉米B302Pro除螨仪在14000Pa吸力不变的情况下,带有拍打功能时,B302的除螨率>90%,不带有拍打功能时,其除螨率<65%。
其奥妙之处,就在于——4.0V型凹凸滚刷,这一国家专利技术。

·4.0V型凹凸滚刷

·拍打试验
相较于市面其它品牌的除螨仪,莱克除螨仪在刷头方面,摒弃了传统直口吸头、拍打锤的设计。采用专利技术--V型凹凸拍打滚刷,综合了拍打锤、毛刷的优势,50000次/分的强力拍打让螨虫更容易被吸除。这种拍打力度相当于普通除螨仪的4-5倍。此外,B302Pro除螨仪配备独立高精密的电机,支持前面的强劲拍打。
由此可见,除螨仪真的可以除螨,同时,具有强劲拍打功能的B302Pro能够实现深层次除螨和过敏原。
深层除螨的核心奥秘
具有大吸力、强拍打、紫外线除菌、超声波抑螨等全面功能的莱克B302Pro除螨仪可以更好地消灭螨虫,也可以预防螨虫滋生。
通过深入的研究实验与用户调研,莱克发现了深层除螨的奥妙。

·吸力测试
莱克吉米B302拥有14000pa的超大吸力,打开除螨仪时,隔着薄被都可以轻松将距离薄被20cm的小球吸起,日常除螨更是不在话下,轻松吸除床褥表面的毛发碎屑。
紫外线杀菌
莱克吉米B302Pro采用的专业UV紫外线杀菌,标示其杀菌率达到99.9%,我们培养采集了标准数量的大肠杆菌进行检测。

·标准体载片测试前

·除菌试验
测试后我们可以看到,莱克吉米B302Pro的杀菌效果值得肯定,大肠杆菌最终消除效果达到99.9%以上。
·标准体载片和测试后载片对比

·紫外线功能展示
智能感应紫外线杀菌的同时开关灵敏更安全。当吸尘器贴近床褥工作时紫外线灯才会亮起,抬起后距离床褥约10cm位置时,紫外线灯就会自动熄灭保护人体健康。

超声波抑螨

·超声波抑螨装置

·超声波抑螨功能展示
超声波抑螨功能可以更有效地抑制螨虫活性,同时,特殊频段的超声波对人体和宠物无害,作用于螨虫的中枢神经,使螨虫停止进食繁殖并逐渐死亡。

·噪音实验
长时间处于噪音环境中容易影响正常生活和休息。在环境噪音为32.7dB的情况下,距离机身50cm位置空转实测噪音是74.4dB,正常运行噪音74.5dB相当于人正常说话的声音,不会影响日常的工作和休息。
【评测点评】深层除螨需要专业的高科技手段。莱克吉米B302Pro除螨仪采用了专利新一代V型凹凸拍打滚刷,50000次/分的强力拍打,搭配14000pa超大吸力、紫外线杀菌和超声波抑螨等技术,拍打深度可达25cm,相比普通吸尘器或没有拍打功能的除螨仪,莱克吉米B302无疑更加专业高效。
健康的家居环境离不开专业的除螨仪,相信莱克吉米B302Pro一定是聪明家庭的不二选择。
